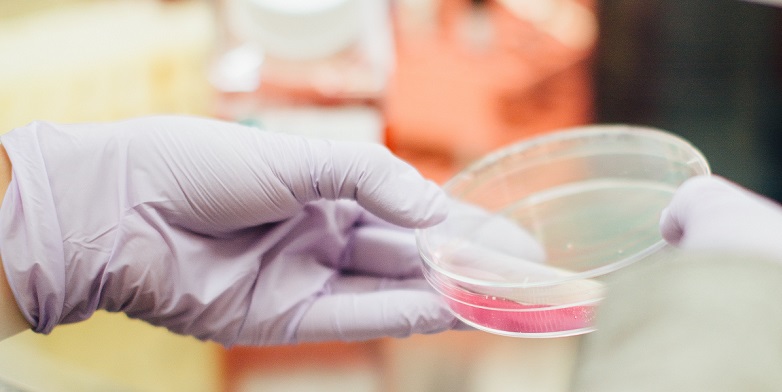

A manufacturer’s breach of its duty to supply products of merchantable quality to consumers does not necessarily entitle third parties within the supply chain (specifically, franchisees) to recover reputational damages, the Ontario Court of Appeal recently held. In 1688782 Ontario Inc. v. Maple Leaf Foods Inc., 2018 ONCA 407, the Court of Appeal reversed a decision granting summary judgment to Mr. Sub franchisees in a class action against Maple Leaf Foods Inc. and Maple Leaf Consumer Foods Inc. (“Maple Leaf”) following a listeria outbreak affecting its products.
Class action background
In the summer of 2008, certain Maple Leaf brand processed meats were contaminated by an outbreak of listeria. Maple Leaf recalled the affected products and temporarily closed the production plant where the infected meat originated. The franchisees of Mr. Submarine Ltd. (“Mr. Sub”) restaurants were impacted by the outbreak. Under their franchise agreement, Mr. Sub franchisees were required to purchase certain products from specified suppliers, which at the time of the listeria outbreak included meat products from Maple Leaf.
A class action was certified on behalf of Mr. Sub franchisees against Maple Leaf. The franchisees claimed damages on the basis that Maple Leaf: (a) negligently manufactured and supplied potentially contaminated meat; and (b) negligently represented that the supplied meats were fit for human consumption. While there was no evidence that any Mr. Sub customer was harmed by any contaminated product, the franchisees claimed economic losses arising from the reputational harm allegedly experienced due to their association with Maple Leaf.
Following certification, Maple Leaf brought a summary judgment motion seeking dismissal of certain claims on the basis that it owed no duty of care to the franchisees. The motion judge concluded that Maple Leaf owed a duty of care to the franchises “in relation to the production, processing, sale and distribution of the RTE Meats” and a duty of care “with respect to any representations made that the RTE Meats were fit for human consumption and posed no risk of harm.”
Ontario Court of Appeal corrects duty of care analysis
On appeal, Maple Leaf contended that the motion judge had erred by finding that: (i) Maple Leaf had supplied with plaintiffs with a defective product which risked compromising human health; (ii) Maple Leaf owed the franchisees a duty of care; and (iii) damages for pure economic loss were recoverable.
The Court of Appeal deferred to the motion judge’s factual finding that Maple Leaf had provided the plaintiffs with a defective product, but found that she had erred in her duty of care analysis. The motion judge had improperly relied upon factually distinguishable cases to conclude that the relationship between Maple Leaf and the franchisees fell into a recognized duty to supply product fit for human consumption. The motion judge did not have the benefit of the Supreme Court’s reasons in Deloitte & Touche v Livent In. (Receiver of), 2017 SCC 63 (“Livent”), in which it cautioned against finding proximity based upon a previously established or analogous category and encouraged courts to carefully examine the particular relationship at issue in each case. For more analysis of the Livent decision, please see our earlier commentary.
The Court of Appeal found Maple Leaf’s duty to supply fit products did not extend to the franchisees’ claim for losses arising from reputational harm. Maple Leaf’s duty to supply meat fit for human consumption – a duty aimed at protecting human health – was owed not to the franchisees, but to the franchisees’ customers. The franchisees, the Court wrote at para 66, “cannot bootstrap their claim for damages for reputational loss to the different duty owed by Maple Leaf to their customers.” To the extent that there may be a duty to supply meat fit for human consumption, the Court explained, it does not extend to damages for pure economic loss claimed by the plaintiffs.
Implications
For defendants in the context of negligence class actions, the Court’s decision, particularly when read in conjunction with the Livent decision, underscores the importance of properly defining the scope of any duty of care arising from a relationship between parties. Defendants and their counsel should consider whether the scope of the alleged duty of care is broad enough to encompass not only the particular relationship at issue, but also the nature of the damages claimed.